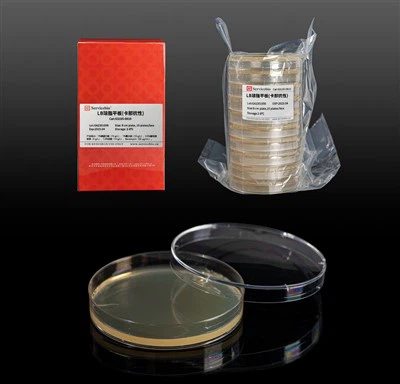
LB寒天プレート（カナマイシン）

製品紹介
|
製品名 |
猫。いいえ。 |
仕様 |
|
アンピシリン、ナトリウム塩 |
GC301004-1g |
1 g |
導入
この製品はアンピシリンナトリウム塩であり、細胞スクリーニングの一般的に使用される濃度は {{0}}ug/ml です。アンピシリンはアンピシリンと同義で、ペニシリンファミリーに属するβラクタム系抗生物質で、βラクタマーゼにも感受性があります。後者はアンピシリンのβラクタム環を切断することができます。アンピシリンは、グラム陽性菌、グラム陰性菌、嫌気性菌を広範囲で阻害します。静菌機構は、ペプチドグリカン合成の最終段階に関与するペニシリン結合タンパク質(PBP)の活性を妨害し、細胞壁の完全性を維持し、細胞壁の正常性を維持するアラニン残基とリジン残基間のペンタグリシン架橋の形成を触媒することです。細菌の増殖。さらに、アンピシリンは、増殖する大腸菌(Col)細菌に対してのみ殺菌効果があります。アンピシリンは、アンピシリンを含む LB または LB プレートの調製および培養細胞の滅菌のため、細胞培養における選択的抗生物質として一般的に使用されます。アンピシリンは、グラム陰性菌とグラム陽性菌をそれぞれ 0.03-3 μg/ml と 0.02-1.5 mg/ml の最小発育阻止濃度 (MIC) で阻害します。オートクレーブした寒天培地または培地は、アンピシリン溶液を添加する前に 45-50 度 C まで冷却する必要があります。アンピシリンを含むプレートは、2-8 ℃で最長 2 週間保存できます。アンピシリンは 37 度で 3 日間安定でした。
基本属性
|
名前 |
アンピシリン、ナトリウム塩 |
|
シノニム |
アンピシリンナトリウム |
|
CASの |
69-52-3 |
|
分子式 |
C16H18N3NaO4S |
|
分子量 |
371.39 |
|
純度 |
85.0% 以上 |
|
見た目(キャラクター) |
白色〜淡黄色の粉末 |
|
保管条件 |
2-8度 |
|
ユニット |
ボトル |
|
仕様 |
1g |
|
パブケム CID |
0 |
|
MDL番号 |
MFCD00064313 |
|
EC番号 |
200-708-1 |
|
関連カテゴリー |
生化学試薬、抗生物質 |
|
溶解性 |
水中100mg/mL |
|
有効 |
36ヶ月 |
保管および取り扱い条件
2-8 度での輸送と保管、36 か月間有効。
注記
安全と健康のため、白衣と使い捨て手袋を着用してください。
セキュリティ情報
|
警告文 |
P261-P280-P342 |
|
RTECSの |
XH8400000 |
|
WGKの |
2 |
注: 製品は最適化およびアップグレードされる可能性があります。実際のラベル情報が優先されます。
研究用途のみ!
人気ラベル: [[productcatename]], 実験器具、メーカー、サプライヤー、工場、カスタマイズ、卸売、購入、OEM、バルク